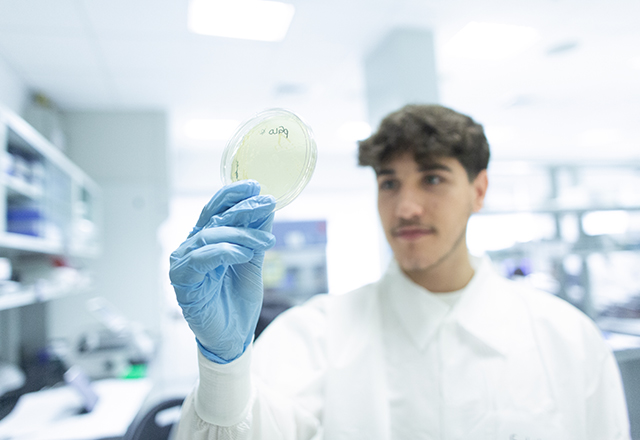
Bachelor of Science in Biological Sciences
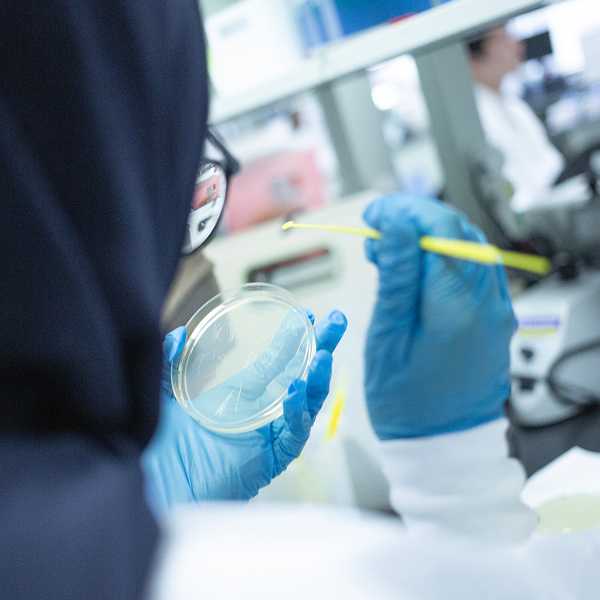
Program at a Glance

Sample text 123
Biological Sciences
Biological sciences students at CMU-Q do more than study science: they learn to follow their curiosity, explore hypotheses, and contribute in a meaningful way as young scientists and researchers.
Bachelor of Science in Biological Sciences
The biological sciences program at the Qatar campus falls within CMU’s Mellon College of Science, which is nationally recognized for its approach to science education.
CMU-Q biological sciences graduates are trained to be:
Biological sciences students have identical graduation requirements as students at Carnegie Mellon in Pittsburgh. Graduates have CMU degrees, conferred from the main campus.

“I’m at the tip of the iceberg and it’s a very deep discipline that I am still learning. But I have my CMU work ethic, and the drive and motivation to inspire future students to pursue science. As Andrew Carnegie says: ‘My heart is in the work’.”
Khalid Al-Naemi, Class of 2019, PhD student, McGill University
Program at a Glance
Students receive rigorous training in biology while building a strong foundation in all of the natural sciences. They study biology at the macro and micro scales, focusing on five core areas:
Students also choose electives in biology, humanities, social science and fine arts, shaping their degree programs according to their unique interests and goals.
Most of our students participate in research during their undergraduate years, often in labs within CMU-Q, in summer research programs or on their own independent projects.

“CMU-Q has such a big emphasis on molecular biology, that really gave me an advantage when I was in grad school. Even now as a practicing genetic counselor, it’s those concepts from undergrad that help me think critically.”
Fatima Amir, Class of 2016, Clinical Genomic Scientist, Ambry Genetics
The Bachelor of Science degree in Biological Sciences has a distinctive core curriculum that provides a foundation in biology, chemistry, computer science, mathematics, and physics. Students also choose electives in biology, humanities, social science and fine arts, shaping their degree programs according to their unique interests and goals.
Biological sciences students who wish to have a specialized focus can tailor their education to include a minor in disciplines such as computational biology or neuroscience. Many students broaden their education by pursuing minors in other disciplines.
Standard Completion Time: 4 Years
Studying biological sciences at Carnegie Mellon is a unique experience. Students take standalone laboratory and research courses where they develop a deep understanding of experimental science. This approach transforms science students into scientists.
Students often delve into more in-depth projects—both student-initiated and in faculty research labs—that are a first step in their careers in research, academia, or medicine.
Frontiers, Analysis, and Discovery in Biological Sciences
In the spring of their first year, students can take an exciting course where they learn to use a cutting-edge genetic modification tool, CRISPR, on yeast and mammalian cells.
Applied Cell Biology
This elective course in the sophomore year allows students to obtain hands-on experience for many of the laboratory techniques that are essential in cell biology research.
Honors Modern Biology
This combination lecture and lab course provides students with a foundation in cellular and molecular biology, reinforcing experimental concepts and the analysis of experimental data.
Experimental Techniques in Molecular Biology
Students conduct experiments in microbial genetics, molecular biology and eukaryotic genetics, with an emphasis on understanding and applying the biological principles of each experiment.
Experimental Biochemistry
Students learn methods for investigating the structure and function of biological molecules, including enzyme kinetics, spectroscopy, tissue culture and flow cytometry. During several experiments, students design their own projects.
Summer Research Institute in Pittsburgh
Biological sciences students can apply to the Summer Research Institute, a program for researching molecular biology and biochemistry at the Carnegie Mellon main campus in Pittsburgh. Research projects involve recombinant DNA techniques and biochemical methods directed toward the functional analysis of proteins and enzymes.
Learn more about undergraduate research opportunities at CMU-Q
CMU-Q provides specialized laboratory spaces where students can learn, investigate and conduct research.
Biology lab
A state-of-the art lab with equipment for cellular, biochemical, and molecular biology research and teaching. In addition to standard laboratory equipment, the lab has equipment for tissue culture, real-time quantitative PCR, next generation DNA sequencing (IonS5), GenomeLab GeXP system, HPLC, and a flow cytometer for cellular analysis. There are two separate labs that are dedicated to faculty and student research, which include several working stations for qPCR, bacterial culture, gel electrophoresis, microscopy, sequencing, and a Biosafety Level 2 tissue culture area.
Chemistry lab
A teaching lab that is equipped with the instrumentation for an upper level quantitative chemistry laboratory (HPLC, ICP-AES, ion chromatography). In addition, there is a separate lab that is dedicated to chemistry faculty and student research.
Career Pathways
Many biological sciences graduates pursue careers in research science in academic, government, biotechnology or pharmaceutical industry laboratories. Others work in the fields of health, forensics, law and education.
Students may choose to pursue graduate studies in a variety of areas such as science, public health, law or business. A degree in biological sciences provides excellent preparation for medical school.
Meet the Faculty
Faculty members include experts in biochemistry, cancer biology, chemistry, CRISPR, genomics, next generation sequencing, precision medicine, and tumor immunology.

Simon Faulkner
Assistant Teaching Professor, Chemistry

Amirah Mohamed Al Sarraj
Library Associate, Collection

Mohammed Al-Sadi
Teaching Assistant, Information Systems

Sara Al Sabbagh
Teaching Assistant

Dina Al Abdi
Program Director of Student Engagement

Mohammed Al-Sadi
Teaching Assistant, Information Systems

Mohamed Al Khudari
Receptionist and Administrative Coordinator
